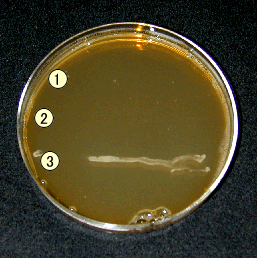

![]()
We have measured the survival ratio of Escherichia coli after adding an aqueous solution of fine scallop shell ceramics powders to an Escherichia coli medium so as to investigate the antibacterial effect. A 0.25% aqueous solution of the shell ceramics is strongly alkaline with pH 12.7. When this solution was added to the medium, the survival ratio became almost 0(15sec) in 1 minute, suggesting that the solution shows a strong antibacterial action.

The viability of Escherichia coli and Staphylococcus aureus cells

Antibacterial examination against Helicobacter pylori.
Scallop shell ceramics powder 1g was added to the distilled water 100m
l, and that supernatant fluid was extracted, and that was made a test
solution. This test solution was diluted by the PBS buffer, and it got
the test solution of the next concentration. The concentration of the scallop
shell ceramics solution : 0%,1%, 10%, 50%, 100%
200μl test solution spread - coated to the plate which scattered a Helicobacter
pylori and it is cultivated. It went by cultivating it in 37℃ for 3 days
under the microaerophile condition . A result of an examination is shown
in the Fig..
The effect that controls the multiplication of Helicobacter pylori isn't found at the cases of the scallop shell ceramics solution of 0% and 1%. It is understood that it is shown that the scallop shell ceramics solution controls the multiplication of Helicobacter pylori in case of 10% and more of concentration .
 |
 |
|
| (a) 0%,PBS buffer only | (b) 1% | |
 |
 |
 |
| (c) 10% | (d) 50% | (e) 100% |
Fig. A result of Antibacterial examination against Helicobacter pylori
The antifungal activity of SSC against 2 species of pathogenic dermatophytes of athlete’s foot
It is interesting that shell ceramics shows antifungal activity agaist Arthroderma vanbreusegheim ① and A. benhamiae ② ,but affected in a less extent to growth of Saccharomyces cerevisiae ③. Clinical trials in Japan and USA to develop the cure for an athlete's foot are now in progress.
 |
|
| SSC absence | SSC present |
| ① Arthroderma vanbreusegheim,② A. benhamiae, and ③ Saccharomyces cerevisiae | |
Bactericidal activity of shell ceramics against MRSA
 |
 |
| SSC absence | SSC present |
Also, shell ceramics shows antimicrobial activities against Salmonella enteritidis, Streptococcus mutans.
The viability of MRSA (No.60905) cells
|
Additive |
0 min |
5 min |
15 min |
30 min |
|
Physiological saline |
100 |
- |
- |
0.882 |
|
SCC Solution(pH12.7) |
100 |
4.3 |
0.02 |
0.0004 |
|
NaOH Solution(pH12.7) |
100 |
- |
* |
0.006 |
*:
Uncountable number of colonies were detected, - : Not
determined.
Viability
(%) against a control
Bactericidal activity of new scallop shell ceramics
Viability (%) against a control

SSC:Scallop Shell Ceramics
We developed the new scallope shell ceramics which had a more powerful antifungal function.
After 1 minute , the viability of MRSA cells was 10-4%.
